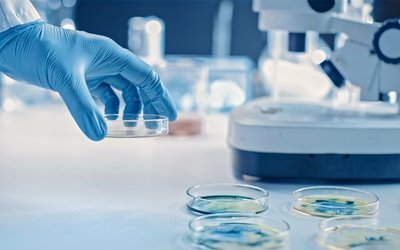
Alterity Therapeutics to commercialise technology that breaks antibiotic resistance

ATH
Director Trades
| Date | Director | Value |
|---|---|---|
| P. Marks | $20,000 | |
| L. Gozlan | $50,000 | |
| B. Meltzer | $25,000 |
Company News

Alterity Therapeutics Confirms Effectiveness of ATH434 Drug Against Advanced MSA
Alterity Therapeutics (ASX: ATH) has released positive topline data from an open label Phase 2 clinical trial of lead candidate ATH434 on 10 patients with advanced multiple system atrophy (MSA). Data from the ATH434-202 trial showed the oral drug conferred a clinical benefit on areas of impairment in MSA and was able to stabilise key […]

Alterity Therapeutics shows positive ATH434 Phase 2 trial results for Multiple System Atrophy
Alterity Therapeutics (ASX: ATH) has announced positive topline results from a Phase 2 clinical trial of lead candidate ATH434-201 on patients with early-stage multiple system atrophy (MSA). ATH434 is an oral agent designed to inhibit the aggregation of pathological proteins implicated in neurodegeneration. MSA is a rare neurodegenerative disease characterised by failure of the autonomic […]

Alterity Therapeutics’ ATH434 trial results suggest improved outcomes for MSA Patients
Alterity Therapeutics (ASX: ATH) has released positive interim data from an open-label Phase 2 clinical trial of its lead asset ATH434, showing stable or improved neurological symptoms in patients with multiple system atrophy (MSA). The analysis of a total of ten participants included clinical and biomarker data on seven who were treated with daily oral […]

Alterity Therapeutics receives funding from Michael J Fox Foundation for Parkinson’s disease clinical trials
Biotech company Alterity Therapeutics (ASX: ATH) has received funding from the Michael J Fox Foundation for Parkinson’s Research to determine optimal dosing of its lead drug candidate ATH434 in Parkinson’s disease clinical trials. This funding for US$495,000 (A$641,500) is the second grant the company has received from the foundation and will be used to evaluate […]

Dr David Stamler steps-up as chief executive officer to lead Alterity Therapeutics’ commercialisation plans
Alterity Therapeutics (ASX: ATH) has appointed Dr David Stamler to lead the company as chief executive officer and spearhead the company’s commercialisation plans for drug ATH434 in treating parkinsonian diseases. Dr Stamler has been with Alterity since June 2017 and will replace Geoffrey Kempler who founded the company in 1997. Mr Kempler remains with Alterity […]
Alterity Therapeutics to commercialise technology that breaks antibiotic resistance
The University of Queensland’s commercial vehicle UniQuest has granted a licence allowing Alterity Therapeutics (ASX: ATH) to use its zinc ionophore technology in combating superbugs. UniQuest has given Alterity exclusive worldwide rights to use its zinc ionophore technology in developing and commercialising therapies that re-sensitise bacteria to antibiotics. Once Alterity has begun receiving revenue from commercialising […]

Alterity Therapeutics collars US patent for next generation compounds
Alterity Therapeutics’ (ASX: ATH) has collared the US patent for its next generation compounds that are designed to assist in treating Parkinson’s and Alzheimer’s as well as other neurodegenerative conditions. The company filed for the patent with the US Patent and Trademark Office back in March, which then went under prioritised examination. It is based […]

New clinical data confirms efficacy of Alterity Therapeutics’ lead drug for treatment of multiple system atrophy
Neurodegenerative disease-focused biotech Alterity Therapeutics (ASX: ATH) has announced that new clinical and experimental pharmacology data for its lead candidate ATH434 has confirmed the drug can reduce alpha-synuclein pathology, preserve neurons and improve motor performance in patients with multiple system atrophy (MSA). The new data was generated from an experiment testing ATH434 in an animal […]

FDA provides development pathway for Alterity Therapeutics’ drug to treat multiple system atrophy
Alternative drug developer Alterity Therapeutics (ASX: ATH) has received guidance from the US Food and Drug Administration (FDA) on the development pathway for its experimental treatment for multiple system atrophy (MSA), a Parkinsonian disorder that currently has no approved treatment. The company, which is dual listed on the ASX and NASDAQ (under ticker code ATHE), […]
